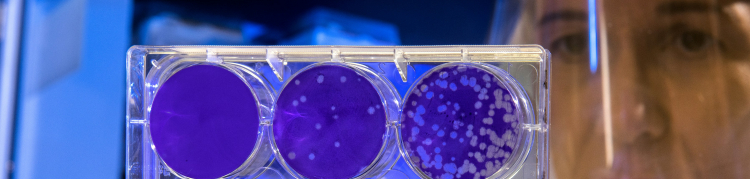
Uma cientista está segurando uma pequena estrutura de vidro contendo seis circunferências compostos por um líquido azul

Aprendendo genética
Compartilhar
Você sabe como os pais transmitem suas características para seus filhos? A genética é uma área da Biologia que estuda os genes, a variação genética e a hereditariedade. Neste conjunto vamos mergulhar neste assunto e aprender mais sobre o funcionamento dos genes.